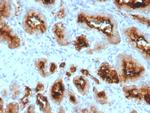
FOLH1/PSMA (Prostate Epithelial Marker) Antibody in Immunohistochemistry (Paraffin) (IHC (P))

Search
NeoBiotechnologies
FOLH1/PSMA (Prostate Epithelial Marker) Monoclonal Antibody (SPM500)
{{$productOrderCtrl.translations['antibody.pdp.commerceCard.promotion.promotions']}}
{{$productOrderCtrl.translations['antibody.pdp.commerceCard.promotion.viewpromo']}}
{{$productOrderCtrl.translations['antibody.pdp.commerceCard.promotion.promocode']}}: {{promo.promoCode}} {{promo.promoTitle}} {{promo.promoDescription}}. {{$productOrderCtrl.translations['antibody.pdp.commerceCard.promotion.learnmore']}}
产品信息
2346-MSM3X-P1ABX
种属反应
宿主/亚型
分类
类型
克隆号
抗原
偶联物
形式
浓度
纯化类型
保存液
内含物
保存条件
运输条件
靶标信息
This gene encodes a type II transmembrane glycoprotein belonging to the M28 peptidase family. The protein acts as a glutamate carboxypeptidase on different alternative substrates, including the nutrient folate and the neuropeptide N-acetyl-l-aspartyl-l-glutamate and is expressed in a number of tissues such as prostate, central and peripheral nervous system and kidney. A mutation in this gene may be associated with impaired intestinal absorption of dietary folates, resulting in low blood folate levels and consequent hyperhomocysteinemia. Expression of this protein in the brain may be involved in a number of pathological conditions associated with glutamate excitotoxicity. In the prostate the protein is up-regulated in cancerous cells and is used as an effective diagnostic and prognostic indicator of prostate cancer. This gene likely arose from a duplication event of a nearby chromosomal region. Alternative splicing gives rise to multiple transcript variants encoding several different isoforms.
仅用于科研。不用于诊断过程。未经明确授权不得转售。
篇参考文献 (0)
生物信息学
蛋白别名: Cell growth-inhibiting gene 27 protein; FGCP; Folate hydrolase 1; Folylpoly-gamma-glutamate carboxypeptidase; GCPII; glutamate carboxylase II; Glutamate carboxypeptidase 2; Glutamate carboxypeptidase II; Membrane glutamate carboxypeptidase; mGCP; N-acetylated alpha-linked acidic dipeptidase 1; N-acetylated-alpha-linked acidic dipeptidase I; NAALADase I; prostate specific membrane antigen; prostate specific membrane antigen variant F; Prostate-specific membrane antigen; PSM; Pteroylpoly-gamma-glutamate carboxypeptidase
基因别名: FGCP; FOLH; FOLH1; GCP2; GCPII; GIG27; mGCP; NAALAD1; NAALAdase; PSM; PSMA
UniProt ID: (Human) Q04609
Entrez Gene ID: (Human) 2346